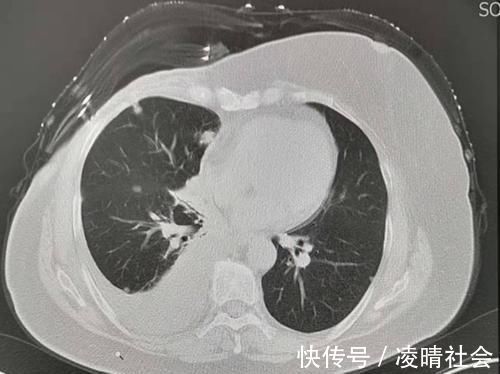
病人|对癌症病人隐瞒病情,是善意的谎言吗?对治疗有帮助吗?

病人|对癌症病人隐瞒病情,是善意的谎言吗?对治疗有帮助吗?
我们这个时代科技虽然已经很发达,但癌症还没有被攻克。恶性肿瘤和心血管疾病是困扰人类寿命的两大杀手,很多中晚期癌症患者,只能想办法延长寿命,难以根治。
很多人“谈癌色变”,有恐惧之心
当然早期癌症已经不可怕了,大多数可以根治!如果发现时就是中晚期,已经没有根治机会,这个时候选择先隐瞒一下病情,保持病人的情绪稳定,有助于顺利开展治疗,延长寿命。
我们遇到过一些病人很固执,非要吵着知道结果,可一旦知道自己所患真的是癌症之后,立刻情绪崩溃,大吵大闹甚至不吃不喝,觉得人生失去乐趣,也不配合治疗,有部分人会迅速衰竭、死亡。对这部分情绪不稳定的病人,隐瞒病情是有益的。
但也有例外,有些病人可以知道病情
有些病人性格很坚韧,愿意主动配合医生治疗,希望对自己的病情有充分的了解,避免走弯路。

文章插图
这是一位乳腺癌手术后的病人,发现双肺多发小结节,考虑转移,很要强的一位病人,听从医生指导做过化疗,平时喜欢旅游,对吃的东西也很上心,偶尔还去跳广场舞。用她的话说,活着就要开心点!多赚一年是一年!
今年已经第8年了,病灶虽然有进展,总体很稳定,56岁发现转移,现在已经64岁了,很坚强的8年抗战:
文章插图
对于这一类病人,是否需要隐瞒病情并不重要!想办法找到高水平的医生,找到敏感的治疗方法更重要!

文章插图
像这位男性病人,49岁查体发现大肝癌,长约15厘米,长满半个肝脏了。病人很配合治疗,也不怨天忧人,手术后已经5年了,没有复发:

文章插图
复查的CT片还能看到肝脏的手术豁口,人类的肝脏有很强的再生和代偿能力。这也是一位很成功的病人!
病人在抗癌的过程中,心态确实很重要,无论做出什么选择,一切要以有利于病人康复为重!
【 病人|对癌症病人隐瞒病情,是善意的谎言吗?对治疗有帮助吗?】偶尔会遇到不孝顺的孩子,明明老人胆子很小,却仍然告诉病人实情,然后轻描淡写来一句“癌症根本治不好”,趁机带老人回家,顺便再骂一句医生黑心,只知道骗钱!还好还好,这种人非常少!
- 病例|河南省疾控中心提醒:应对奥密克戎,这件事很重要!
- 国人历来重视精神对治疗疾病、养生保健的重要作用|心平气和,有益健康的“良药”
- 救治|广东珠海:奥密克戎感染后症状相对较轻 新增病例年轻人偏多
- 丝瓜|常吃丝瓜对身体好,但丝瓜不能与一物同吃,爱吃的人得忌口了!
- 德尔塔|珠海:奥密克戎感染后症状相对较轻,新增病例年轻人偏多
- 浴室里的“它”,可能是癌症帮凶,多数人洗澡时比较喜欢用
- 体内有癌,腰背先知晓?出现这2种标志,或是癌症“警告”?
- 德尔塔|广东珠海:奥密克戎感染后症状相对较轻 新增病例年轻人偏多
- 那过|孕期吃药对胎儿有没有影响
- 鼻涕|鼻炎为什么难以根治?对于鼻炎,我与它势不两立
